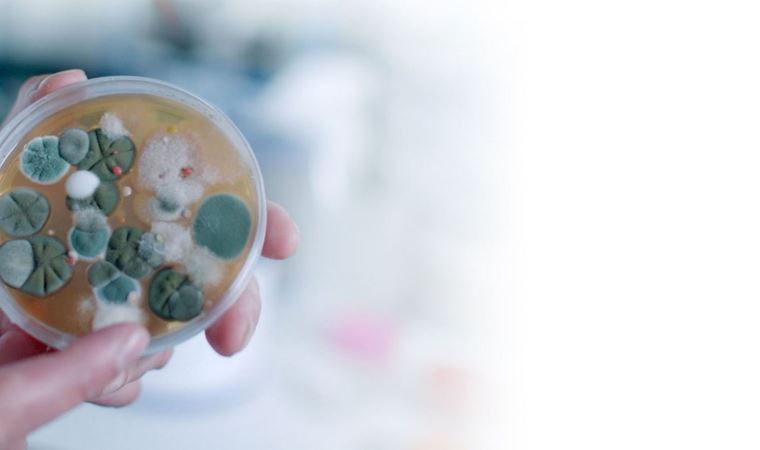

Çocuk Alerji ve İmmunoloji Uzmanı Doç. Dr. Şule Çağlayan Sözmen, ağır metal, bakteri ve mantarların solunum (astım, zatürre) ve uyku bozukluklarına, doğurganlıkta azalma, kemik yapısında zayıflık ile böbrek, karaciğer sorunlarına neden olduğunu söyledi.
Global teknoloji şirketi Dyson, İstanbul Üniversitesi İstatistik Uygulama ve Araştırma Merkezi’yle evlerde maruz kalınan kirleticilerin insan sağlığına olumsuz etkilerini ortaya koymak amacıyla ‘Ev Tozu Araştırması’ yaptı. Türk halkının temizlik alışkanlıklarına yönelik bilgi edinilmek hedefiyle de gerçekleşen çalışmada dikkat çeken sonuçlar elde edildi.
İstanbul’da 30 evin salon ve yatak odalarından 60 farklı noktadan toz örnekleri alınarak 108 farklı analiz yapıldı. Araştırmanın detaylandırılması için toz örnekleri alınan evlerde yaşayan bireylerle, demografik yapıları, temizlik alışkanlıkları, sahip oldukları alerjik rahatsızlıkları ve solunum yolu problemleri hakkında anket çalışması yapılarak konutlarda bulunan alerjenlerle hastalık ilişkilendirilmesi üzerine analizler yapıldı. Çalışmada, evlerin bulunduğu lokasyonlar, oturulan binaların kat sayısı, evlerde yaşayan birey ve çocuk sayısı, çocukların yaşları, evcil hayvan besleme durumu gibi kriterler gözetildi.
ARAŞTIRMANIN SONUÇLARI
Araştırmaya göre kişilerin yüzde 75’i evlerinde bulunan toz tiplerinin farkında değil. Evlerin yüzde 93’ünde 14 farklı ağır metal, yüzde 43,3’ünde 7 farklı bakteri ve yüzde 26,7’sinde tek tür mantar türü bulundu. Yani her 10 evden 9’unda metal ve ağır metale rastlanırken evlerde görülen ortalama metal sayısı bakteri sayısından yüzde 150 daha fazla.
Çalışma yürütülen evlerin yüzde 10’nunda; bireyler üzerindeki tehlikeli etkilerinden doğurganlık engelleyici özelliğiyle dikkat çeken, büyük iş ve üretim makinelerinden, kumaş boyası, mıknatıs özellikli aletler ve elektronik cihazlardan ortaya çıkan ‘Molibden’ ağır metaline yüksek miktarda rastlandı.
BU MANTAR TÜRÜ AĞIRLIK OLARAK YATAK ODASINDA TESPİT EDİLDİ
Özellikle evcil hayvanlar, sinekler ve temas yoluyla yayılan bakterilerden ‘Coccus’ türüne evlerin yüzde 93,3’ünde rastlanırken, evlerin çoğunda (yüzde 57) 7 bakteriden (Coccus, Bacillus, Staphylococcus, Streptococcus, Diplococcus, Coccobasilli ve Basillus) ortalama 4’ü bulunuyor. Bireylerin uyuduğu yerdeki oksijen dengesinin bozulmasına, kaliteli bir uyku uyuyamamasına, burun tıkanıklığına, ağız ve boğaz gibi nefes yollarının kurumasına ve tahribata sebep olan ‘Hyphae’ mantarına evlerin yüzde 26,7’sinde rastlandı. Bu mantar türü ağırlık olarak yatak odasında tespit edildi.
İstanbul Üniversitesi İstatistik Uygulama ve Araştırma Merkezi Müdürü Doç. Dr. Haluk Zülfikar, 3 buçuk ay sürede araştırmada, evlerdeki tozların detaylı bir analizden geçtiğini vurguladı. Doç. Dr. Zülfikar, “Evi, binayı ve ilçeyi seçerken sağlığı birinci sıraya koymalıyız. Yatak odaları güneş görmelidir, karanlık, nemli odaları yatak odası yapmayın. Salonda yaşıyoruz ama yaşamayı da bilmiyoruz, yemek yiyoruz, uyuyoruz, çamaşır kurutuyoruz. Ama temizlik noktasında sıkıntılarımız var. Temizlikte havalandırma nedir? Ne kadar da bir pencere açılmalı? Oksijenin alınması ne işe yarar? Bunlar bizim yaptığımız ölçümlerde bilinmiyor. Bilinme oranı yüzde 10’un üstüne çıkmadı” dedi.
HER GÜN EVİ EN AZ 15 DAKİKA HAVALANDIRIN
Doç. Dr. Zülfikar, “Her gün mutlaka pencereleri açıp en az 15 dakika evi havalandırmalıyız. Yaptığımız araştırmaya göre kişiler, bilinçli olarak haftada bir kez evini havalandırıyor. Sabah kalkınca yatak odalarındaki pencereyi açmak zorundasınız çünkü gece oksijeni tüketiyorsunuz. Oksijen olmayınca yatak odalarında yüzde 26,7 mantar ürüyor. Mantar zihin hastalığı yapıyor, astıma, alerjiye neden oluyor. Çalışmaya katılanların yüzde 58’i evinin temiz olduğunu söyledi. Yüzde 42’si ise ev temizliğinin süper olduğunu belirtti. Hiç kimse evinin temiz olmadığını düşünmüyor” diye konuştu.
“ÇORAPLARLA MANTAR VE BAKTERİ TAŞINIYOR”
11 günde bir çorabını değiştiren insanların olduğunu dile getiren Doç. Dr. Zülfikar, “O çoraplarda ciddi miktarda mantar ve bakteri taşınıyor. Bu bakteri ve mantarlar yatak odalarına kadar gidiyor. 2016 yılında astım ve alerjisi olanların sayısı yüzde 26,7’yken bugün yüzde 64’e çıktı. Ağır metallerden kurtulmak istiyorsanız apartmanların 11’inci katı ve daha üstünde oturmalısınız. Türkiye’de ciddi derece ağır metal var. Hanelerde ağı metal oranı yüzde 93. Demir, bakır, çinko gibi sağlığı olumsuz etkileyen ağır metaller var” ifadelerini kullandı.
“AĞIR METALLER KANSERE, DİKKAT BOZUKLUĞUNA NEDEN OLUYOR”
Her geçen gün dünyada alerjik hastalıkların çok arttığını söyleyen Çocuk Alerji ve İmmunoloji Uzmanı Doç. Dr. Şule Çağlayan Sözmen ise, “Özellikle İstanbul gibi endüstrileşmiş, kentsel yaşamın hakim olduğu illerde ağır metal yükü çok fazla. Çocukluk çağında çok sık görülen kronik hastalık astım çocukların kan, kurşun düzeyiyle direk olarak ilişkili bulunmuş. Ağır metaller birçok kronik hastalığa neden oluyor, küçük yaşlardan beri maruz kalmak karaciğer, böbrek fonksiyonlarında bozulmaya, vücuttaki tüm enzim sistemlerinin olumsuz etkilenmesine, kansere, dikkat bozukluğuna yol açar” dedi.
"EGZAMALARIN OLUŞMASINA NEDEN OLUYOR"
Bakterilerin her yerde olduğunu vurgulayan Doç. Dr. Sözmen, “Bakterilerin sayısının artması solunum yolu hasarı yapıyor. Egzamaların oluşmasına neden oluyor, bağışık sisteminin düşük olduğu zamanlarda zatürre, kalp kapakçığı hastalıkları ve bunların neden olduğu enfeksiyonlar artırıyor. İstanbul’da deniz kenarında yaşıyoruz, rutubet çok yüksek nefes alamıyoruz. Hastalar genelde sabah kalktıklarında burunlarının tıkalı, ağızlarının kuru olduğunu söylüyor. Böyle bir alerjik zemin varsa mantarda varsa çok sıkıntılı bir süreç oluyor. Alerjisi olan kişiler mantara maruz kalınca mevcut olan burun tıkanıklığı, hapşırık, öksürük, bronşların tıkanması gibi rahatsızlıkları alevlendiriyor” diye konuştu.